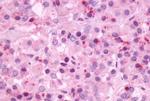
NMBR Antibody in Immunohistochemistry (Paraffin) (IHC (P))

Search
Invitrogen
NMBR Polyclonal Antibody
{{$productOrderCtrl.translations['antibody.pdp.commerceCard.promotion.promotions']}}
{{$productOrderCtrl.translations['antibody.pdp.commerceCard.promotion.viewpromo']}}
{{$productOrderCtrl.translations['antibody.pdp.commerceCard.promotion.promocode']}}: {{promo.promoCode}} {{promo.promoTitle}} {{promo.promoDescription}}. {{$productOrderCtrl.translations['antibody.pdp.commerceCard.promotion.learnmore']}}
产品信息
PA1-23590
宿主/亚型
分类
类型
抗原
偶联物
形式
浓度
规格
保存条件
运输条件
RRID
产品详细信息
PA1-23590 detects Neuromedin B Receptor in Human samples.
靶标信息
NMBR, also known as neuromedin B receptor, a Bombesin Receptor, activates phospholipase and protein kinase C and enhances calcium mobilization. It binds neuromedin B, a potent mitogen and growth factor for normal and neoplastic lung and for gastrointestinal epithelial tissues. Neuromedin B receptor expression has been reported in brain, particularly the olfactory bulb and thalamus, and in colon, liver, placenta, testis, spinal cord, and gastrointestinal tract. In addition, it has been shown to be present in cancer of the lung, ovary, and prostate. ESTs have been isolated from B-cell/lung/testis and brain libraries.
仅用于科研。不用于诊断过程。未经明确授权不得转售。